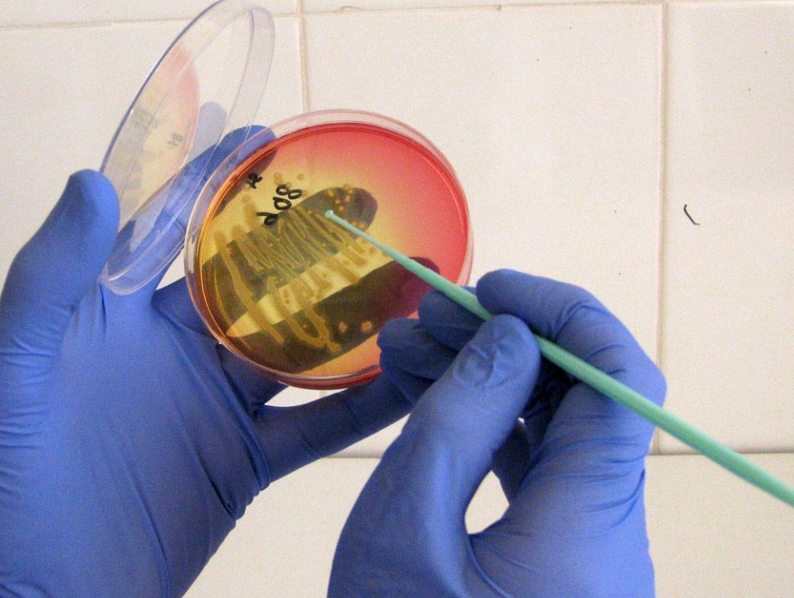
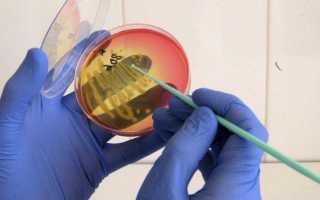

Одной из самых распространенных скрытых инфекций является ureaplasma species (уреаплазма специес). При инфицировании человек может не испытывать особого дискомфорта и вести привычный образ жизни, заражая своих партнеров. При длительном течении ureaplasma spp у женщин вызывает воспалительные заболевания репродуктивных органов и способно стать причиной бесплодия, выкидышей и родовых осложнений. Обнаружить возбудителя можно с помощью лабораторных анализов. Лечение длительное и проводится посредством антибиотиков.
Уреаплазма специес – это микроорганизм, не имеющий клеточной оболочки и дезоксирибонуклеиновой кислоты (ДНК), поэтому он занимает промежуточное положение между бактериями и вирусами. Он провоцирует развитие бессимптомной инфекции мочеполовой системы. Термин «специес» объединяет паразитов двух видов — ureaplasma parvum (уреаплазма парвум) и ureaplasma urealyticum (уреаплазма уреалитикум), которые отличаются между собой. При проведении анализов наиболее часто выявляют уреаплазма специес, то есть сразу обе формы.
Микроорганизм относится к негонококковым возбудителям, что делает его особенно опасным для уретры. Заболевание, которое он провоцирует — уреаплазмоз — является распространенным и диагностируется примерно у 1/3 людей с воспалительными патологиями репродуктивных органов. Чтобы был поставлен такой диагноз, в анализах не должно быть выявлено других возбудителей венерических болезней.
В 70-е года 20 века уреаплазма считалась условно-патогенным микроорганизмом, который может присутствовать в микрофлоре здоровых женщин, поэтому лечение не проводилось. Современная российская медицина на основании длительных исследований пришла к выводу, что это заболевание необходимо устранить, особенно при планировании детей.
Колонизация уреаплазм вызывает ряд болезней мочеполовой системы:
Заболевание
Характеристика
Нет доказанных фактов, что уреаплазма вызывает воспаление влагалища, но ее часто обнаруживают в микрофлоре при вагините
Острый уретральный синдром
Микроорганизм уреаплазма способен вызывать частое и неудержимое мочеиспускание у женщин без патологических изменений в моче
Уреаплазму часто находят у женщин с поражениями шейки матки
Неоплазии шейки матки
Согласно исследованиям, существует связь между уреаплазмой, папилломавирусной инфекцией и неоплазией шейки матки
Уреаплазму часто обнаруживают у женщин с цервикальной недостаточностью, патологиями течения беременности и эндометритом. В редких случаях этот микроорганизм приводит к бесплодию.
Основная причина инфекции – половой акт с зараженным партнером. Этот микроорганизм легко прикрепляется к клеткам и сперматозоидам и может попасть в верхние отделы мочеполовой системы женщины. Благодаря микроскопическим размерам он способен свободно проникать даже через поры презерватива.
Заболевание передается от больной женщины к плоду во время беременности и родов. У 30% новорожденных девочек, чьи матери инфицированы уреаплазмой, выявляют бактерии во влагалище и носоглотке. Существует низкий риск заражения бытовым путем, например, в общественном туалете или при посещении загрязненного бассейна.
Патогенные бактерии обитают на слизистых оболочках – в области половых органов и в редких случаях – в носоглотке, легочной и печеночной ткани. Поэтому для инфицирования достаточно поцелуя. Способствовать заражению могут следующие причины:
- Раннее начало половой жизни.
- Частая смена сексуальных партнеров.
- Прием гормональных препаратов.
- Сниженный иммунитет.
- Злоупотребление местными антисептиками.
- Переохлаждения.
- Ранее перенесенные венерические заболевания.
Заразиться уреаплазмой можно при переливании крови и пересадке органов, но основным путем передачи инфекции является половой акт.
Уреаплазма редко проявляет себя сразу после попадания в организм. Обычно первые симптомы можно заметить только при снижении иммунитета и гормональных сбоях, когда заболевание уже переходит в хроническую форму. Классическими признаками инфицирования являются:
- Мутные и слизистые выделения из влагалища.
- Тянущие боли внизу живота.
- Отек гениталий.
- Болезненность при мочеиспускании.
- Коричневые выделения.
- Жжение при опорожнении мочевого пузыря.
- Дискомфорт во время полового акта.
Женщины, страдающие уреаплазмозом, жалуются на выделения из влагалища и боли. Этот симптом свойствен многим венерическим заболеваниям и воспалительным неинфекционным патологиям мочеполовой системы. У некоторых женщин уреаплазма никак не проявляется, но они остаются источником инфекции.
Для выявления уреаплазмы проводят несколько анализов:
- Полимеразная цепная реакция, или ПЦР (PCR, или polymerase chain reaction).
- Культуральное исследование.
- Иммуноферментный анализ.
ПЦР-диагностика позволяет выявить ДНК возбудителя в исследуемом материале, которым обычной служит отделяемое из половых органов (соскоб из канала шейки матки, уретры, стенок влагалища). Женщинам рекомендовано проводить Такой анализ до менструации или через 2 дня после нее. Положительный результат теста указывает на наличие уроплазматической инфекции. Отрицательный — не исключает присутствие возбудителя, а показывает ее отсутствие в материале.
Культуральное исследование проводят при положительном результате ПЦР-диагностики для определения общего количества микроорганизма и его чувствительность к антибиотикам. Анализ подразумевает помещение биоматериала в специальную питательную среду, где возможен активный рост уреаплазмы. Недостатком бактериального посева является его длительность проведения – около 8 дней. При расшифровке нормой считается 10 в 4 степени КОЕ/мл.
Иммуноферментный анализ определяет наличие антител в организме к тому или иному возбудителю и титр обнаруженных бактерий. Исследуемым материалом является кровь, которую помещают на специальную полоску с антигенами. Для получения данных обычно достаточно одного дня, но организм не всегда вырабатывает антитела, поэтому даже при наличии инфекции результат может быть отрицательным. Нормой является отрицательный результат.
При наличии жалоб пациентки на зуд и жжение в области половых органов врач назначает дополнительные обследования – анализ мочи, УЗИ органов малого таза, микроскопическое исследование микрофлоры. Это позволит выявить другие заболевания, развившиеся на фоне уреаплазмоза.
Во время планирования беременности женщинам рекомендовано сдать все анализы на половые инфекции. Многие пренебрегают этой процедурой и узнают о наличии уреаплазмы в период вынашивания ребенка. В таком случае требуется обязательное лечение, так как инфекция может быть передана плоду. Если у беременных уреаплазмоз является причиной воспалительных патологий репродуктивных органов, то у новорожденного он способен привести к следующим заболеваниям:
- Острая пневмония.
- Заражение крови (в редких случаях).
- Менингит.
- Бронхолегочная дисплазия.
Уреаплазмоз может стать основной причиной внематочной беременности, преждевременных родов, послеродового эндометрита, выкидыша. Чтобы этого не произошло, требуется незамедлительное лечение, а при большом количестве уреаплазмы в организме его назначают независимо от срока.
Лечение уреаплазмоза осуществляется антибиотиками. Этот микроорганизм нечувствителен к пенициллинам и цефалоспоринам, поэтому препаратами выбора являются доксициклин и макролиды, к которым относятся:
- Азитромицин.
- Кларитромицин.
- Джозамицин.
- Рокситромицин.
Если уреаплазмы имеют устойчивость к указанным препаратам, лечение проводится с помощью антибиотиков фторхинолонового ряда – Офлоксацин и Левофлоксацин. При беременности терапию осуществляют макролидами (Джозамицин), начиная не раньше 2-го триместра. Если заболевание имеет хронический характер, врач назначает 2-3 антибиотика, а длительность лечения доходит до нескольких месяцев.
Схемы терапии могут включать антибактериальные свечи или растворы для спринцевания. При снижении иммунитета назначают иммуномодуляторы – Циклоферон или Виферон. При длительном течении инфекции для профилактики образования спаек в малом тазу показаны ферменты – Лонгидаза, Вобэнзим.
Средняя длительность курса лечения составляет 20 дней. Во время терапии важно соблюдать диету и отказаться от соленых, жареных, острых и копченых блюд, алкоголя. Запрещены половые контакты. После окончания курса не менее чем через месяц женщине необходимо пройти повторное обследование. Если при ПЦР-диагностике уреаплазма будет снова обнаружена, подбирается новая схема терапии.
Лечение уреаплазмоза – длительный и дорогостоящий процесс, а после 20 дней приема антибиотиков очень часто ПЦР фиксирует другую форму микроорганизма, что требует повторного назначения препаратов.
Уреаплазмоз является заболеванием, которое вызывает воспалительный процесс в мочеполовой системе. Оно не считается венерическим, хотя и передается половым путем. При возникновении болей во время мочеиспускания, появлении непонятных выделений, а также если семья долгое время пытается завести ребенка, но у них не получается, врач назначает анализ на уреаплазму. Исследование может производиться различными методами, которые имеют свои плюсы и минусы.
В каких случаях назначается и когда необходим повторный анализ
Когда необходимо сдавать анализ, признаки у представительниц прекрасного пола:
- тянущие боли внизу живота;
- специфические выделения из половых путей (слизистые или слизисто-гнойные);
- покраснение в области уретры;
- неприятные ощущения при мочеиспускании (зуд и жжение);
- кровянистые мажущие выделения в периодах между менструациями;
- болевые ощущения во время или после полового акта;
- отечность влагалища.
Если посмотреть, как выглядит уреаплазмоз у мужчин на фото, то можно заметить внешние симптомы. Возникают они в виде покраснения и отечности уретры. Заболевание проявляется у мужчин следующим образом:
- жжение, зуд в уретре и во время мочеиспускания;
- скудные, прозрачные выделения из уретры (слизистые или слизисто-гнойные);
- частые позывы сходить в туалет;
- болезненные ощущения, отдающие в прямую кишку.
Также, анализ на уреаплазму назначается в следующих ситуациях:
- при планировании беременности;
- наступление беременности;
- признаки воспалительного процесса у мужчин в мочеиспускательном канале и простате;
- симптомы и проявления воспаления влагалища, шейки матки, уретры у женщин;
- наличие выкидышей в анамнезе;
- подозрение на бесплодие;
- когда человек является донором спермы.
Причиной для исследований может быть уреаплазмоз после лечения (для предотвращения рецидивов назначается повторный анализ). Вторичное заболевание может возникнуть в результате ослабления защитных сил организма.
Иммунная система может дать сбой под воздействием следующих факторов:

- частые переохлаждения, перегревы, пребывание на сквозняках;
- сопутствующие патологические состояния;
- употребление алкоголя, наркотиков, курение;
- нездоровое питание;
- постоянные стрессы, переживания;
- хронические депрессии;
- частое переутомление, недосып;
- плохая экологическая обстановка.
Также обследование необходимо в первые дни жизни новорожденного, если инфекция была во время беременности у матери. В этом случае патогенный микроорганизм может перейти к младенцу по родовым путям во время появления на свет. Инфицирование малыша может вызвать для него тяжелые последствия.
Виды анализов
Обследование на уреаплазмоз может производиться следующими методами диагностики:
- ПЦР (называется полимеразной цепной реакцией). При таком диагностическом мероприятии берется соскоб на наличие инфекции.
- ИФА (иммуноферментный анализ). Такой вид исследования подразумевает под собой забор крови для изучения.
- Анализ на бактериальный посев (культуральный метод).
Проверить также необходимо состав мочи. Сдавать анализы на наличие патологического состояния обязательно при возникновении подозрений на него. Таким образом получится своевременно выявить инфекцию и начать необходимое лечение. Чем раньше будет начата терапия, тем легче будет избавиться от воспалительного процесса без возникновения осложнений. Методы обследования на наличие патогенных микроорганизмов одинаковы для пациентов любой половой принадлежности и возрастной категории.
Для данного обследования берется соскоб (мазок) со слизистых оболочек мочеиспускательного канала или половых органов. Также, может быть использован другой биологический материал для изучения его состава под микроскопом в лабораторных условиях.
ПЦР ureplasma spp позволяет не только обнаружить патогенные микроорганизмы, но и определить их количественный показатель. Полимеразная (полимерно) цепная реакция выявляет даже самые опасные типы заболевания. Диагностическое исследование способно обнаружить, выявить количество и определить место локализации инфекции в 99% случаев.
Иммуноферментный анализ
Такой анализ крови на патоген уреаплазмы применяется редко. Это связано с тем, что он предоставляет меньше информации, чем полимеразная цепная реакция или бактериальный посев. Такой метод, как правило, применяется в качестве дополнительного обследования для подтверждения диагноза.
ИФА (иммуноферментный анализ) определяет иммуноглобулины в кровяной жидкости. Так как данные элементы принадлежат к различным группам, каждый вид в анализе указывается по отдельности. Наличие антител типа М говорит о начале воспалительного процесса и включении защитных сил в организме. Элементы из группы G свидетельствуют о продолжительном течении заболевания или об излечении от него (так как этот тип иммуноглобулинов наблюдается в крови и после проведенной терапии).
Анализ мочи
Анализ мочи берется в утреннее время. Урина для обследования должна находиться в организме не более 6 часов. Перед забором материала необходимо тщательно следить за интимной гигиеной.
Биологический материал (урину) собирают в специальный стерильный контейнер. В этот же день он относится в лабораторию для исследования. Если в моче присутствуют патогенные микроорганизмы, они начинают образовывать колонии. Если вы проходите курс терапии медикаментами и не могли на время отменить лечение, сообщите об этом лаборанту. Это поможет исключить ошибки в результатах исследования.
При сдаче мочи на исследование в лабораторию могут быть также выявлены сопутствующие патологические состояния. Для подтверждения их наличия назначаются дополнительные диагностические мероприятия. Только после этого может быть поставлен точный диагноз и назначено эффективное лечение.
Бакпосев на уреаплазму
Уреаплазма в мазке может быть обнаружена, если назначается культуральное обследование. Бакпосев на микроорганизм дает количественное определение патогена уреаплазмы. Для этого биологический материал помещается в специальную питательную среду выращивания. Под микроскопом изучается количество бактерий на 1 мл сданной жидкости. Также проводится исследование на чувствительность к антибиотикам различной группы.
Посев на уреаплазму с определением чувствительности к антибиотикам берется со слизистых оболочек мочеполовых путей. Мазок у женщин на инфекцию производится с внутренних стенок влагалища. Бакпосев на патоген у мужчин собирается с уретры. При этом изучают также эякулят.
Бактериальный посев на уреаплазму, парвум, spp и количественный анализ (ПЦР) активно применяются для выявления в организме патогенных микроорганизмов. Оба метода диагностики имеют свои плюсы в той или иной ситуации. Мазок на ПЦР (количественное определение) помогает выявить вид Mycoplasma genitalium. Мазок у женщин и мужчин культуральным методом рекомендуется для выявления типов Mycoplasma hominis и Ureaplasma spp.
Как подготовиться
Подготовка к анализу мазка ПЦР производится следующим образом:
- за два дня до сдачи анализа необходимо приостановить употребление антибиотиков;
- за два дня не использовать средств местного назначения и контрацептивов;
- подмыться необходимо с вечера без использования средств для гигиены, утром процедуры проводить нельзя;
- за два дня до анализа не вступать в половой контакт;
- перед сдачей анализа не ходить в туалет три часа;
- нежелательно делать мазок после кольпоскопических проб.
Подготовка к анализу ИФА:
- Кровь нужно сдавать на голодный желудок. Последний прием пищи должен быть как минимум за двенадцать часов до исследования.
- Как минимум за тридцать минут до сдачи анализа нельзя курить.
- За два-три дня до забора крови не рекомендуется употреблять спиртные напитки.
- Запрещен прием некоторых медикаментов. Если вы проходите какой-то курс терапии препаратами, сообщите об этом врачу.
Подготовительные мероприятия к бакпосеву:
- у женщин материал берется не ранее двух-трех дней после окончания менструации;
- за день до сдачи анализа нельзя принимать антибактериальные препараты;
- за два дня до бакпосева воздержитесь от полового контакта;
- за день до анализа не используйте местные препараты и контрацептивы;
- за семь-десять дней прекращается лечение вагинальными средствами, антибиотиками;
- подмываться можно только вечером без мыла, утром это делать нельзя;
- воздержаться от похода в туалет за два-три часа до сдачи анализа.
Перед сдачей мочи необходимо за день перестать есть жареное, соленое, сладкое, пить алкоголь и кофе.
Перед сдачей мочи необходимо за день перестать есть жареное, соленое, сладкое. А также пить алкоголь и кофе. Перед сбором урины нужно хорошо подмыться без мыла. Если вы принимаете какие-то лекарственные препараты, сообщите перед забором мочи об этом специалисту. Сбор урины необходимо производить в стерильную, сухую емкость. Специальный контейнер можно приобрести в любой аптечной сети. Мочу нужно собирать в количестве 20-30 мл и хранить в прохладном месте до передачи в лабораторию.
Как берут анализ на уреаплазму у мужчин
Мужчины сдают для выявления патогенного микроорганизма соскоб с поверхности уретры, мочу, эякулят. В этом биологическом материале наблюдается наибольшее скопление инфекции. Как берут анализ на уреаплазму (соскоб) у мужчин:
- Перед тем как сдается анализ, нельзя ходить в туалет два-три часа. Это необходимо, чтобы на поверхности слизистой оболочки накопилось как можно больше патогена.
- Биологический материал для полимеразной цепной реакции и на бакпосев берется при помощи тонкого зонда со щеточкой на конце.
Сдать анализ (ПЦР, бакпосев) на уреаплазму мужчине необходимо сразу же при возникновении подозрений на воспалительный процесс. Это, конечно, довольно неприятная процедура, но при правильных действиях медицинского работника болезненных ощущений не вызывает.
Как берется анализ на уреаплазму у женщин
Анализ на уреаплазмоз, микоплазму у женщин берется при помощи мазка из уретры, влагалища, шейки матки. Забор биоматериала назначают в зависимости от сопутствующих заболеваний, цели проведения исследования.
Анализ на уреаплазму у женщин при подозрении на уретрит, дисбиоз, вагинит берется со стенок влагалища. При наличии других сопутствующих заболеваний мочеполовой системы, мазок снимается с цервикального канала шейки матки. Как сдавать анализ:
- Чтобы взять мазок, специалист сажает женщину на гинекологическое кресло.
- При помощи специального зонда-щеточки снимается соскоб.
- Гинеколог пишет направление и отправляет биоматериал на исследование в лабораторию.
Как правило, процедура не доставляет болезненных ощущений. Может возникнуть лишь небольшой дискомфорт, который быстро проходит.
Расшифровка анализа на уреаплазму производится исходя из показателей нормы
Расшифровка результатов
Расшифровка анализа на патоген уреаплазму производится исходя из показателей нормы. Если даже в биоматериале уреаплазма 10 обнаружена, это вовсе не свидетельствует о том, что человек болен и ему необходимо лечение. Не пытайтесь самостоятельно диагностировать себе патологическое состояние.
При ИФА на бланке с результатом анализа будет графа «антитела в пробе». Когда уреаплазма в биоматериале не представляет опасности, рядом с этой графой должно стоять слово «норма». Показатели в цифрах уреаплазмы могут в разных медицинских учреждениях различаться. Поэтому расшифровка анализа производится по слову «норма». Бывает, что анализ на ureaplasma urealyticum parvum или на другие виды бывает сомнительным. В этом случае назначаются дополнительные исследования для выявления возбудителей инфекции.
Нормальное значение, если анализ берется культуральным методом или при помощи ПЦР — не более 10 в 4 степени КОЕ на 1 мл. При таких исследованиях если уреаплазма 10 больше 4, 5 степени, это свидетельствует об активности патогенного микроорганизма. В этом случае назначается необходимое лечение.
Показатели в норме
Норма уреаплазмы в мазке у мужчин и женщин одинаковая. Референсные значения «не обнаружено» говорят о том, что инфекции в организме нет.
В анализах ПЦР показатели (титры) 10*3 свидетельствуют о том, что количество патогенов в биоматериале в норме. То есть уреаплазма 10 до 3 степени означает, что микроорганизмы присутствуют, но в такой концентрации не способны вызвать заболевание. Посев на уреаплазму нормальные показатели — в концентрации менее 10 в 4 степени.
У женщин норма мазка предельная такая же, как и у мужчин. Максимальная норма при методе ПЦР и при бакпосеве одинаковая. Уреалитикум, специес, парвум у женщин, мужчин в анализе должен иметь уровень 10*4-10*5. При таком допустимом значении могут быть назначены дополнительные обследования.
Расшифровывать самостоятельно результаты анализов и ставить себе диагноз не стоит. Какое считается нормой значение уреаплазмы, может определить только высококвалифицированный специалист. Показатели могут меняться под воздействием различных факторов.
Отклонения от нормы
Показатель уреаплазма 10 (ДНК ureaplazma urealyticum и другие виды) в 5 степени считается гранью между нормой и ее отклонением. В этом случае специалист принимает решение о дальнейших действиях. Может быть назначено дополнительное обследование или лечение.
Когда в организме присутствует уреаплазма парвум, igg или другие виды и норма отклонена от необходимых показателей, назначается, как правило, терапия поддерживающими препаратами для укрепления иммунной системы. Чем сильнее защитные силы организма, тем ниже риск активации патогенных микроорганизмов.
Если даже были выявлены специфические фрагменты уреаплазмы ДНК в биологическом материале в количестве превышающем норму, паниковать не стоит. Определить, несут ли в такой концентрации патогенные микроорганизмы опасность здоровью того или иного пациента, может только высококвалифицированный специалист. Как говорилось ранее, норма у женщин и мужчин может меняться в зависимости от различных факторов.
Расшифровка при беременности
Уреаплазма при беременности на любых сроках считается в норме 10 в 4 степени. При большом показателе назначается эффективное лечение. Во время вынашивания плода при подозрении на инфекцию как правило, назначается культуральный метод диагностических мероприятий. Он дает возможность подобрать правильную схему терапии антибиотиками.
Завышение показателей может быть из-за ослабления иммунной системы беременной женщины. При вынашивании плода нахождение в мочеполовых путях патогенного организма в пределах нормы считается допустимым. В лечении в этом случае нет необходимости. При уровне концентрации болезнетворного микроба 10 в пятой степени и более врач проводит дополнительные обследования и назначает эффективные терапевтические мероприятия, которые не навредят будущей матери и ее ребенку.
Лечить патологическое состояние во время беременности необходимо в обязательном порядке. Если этого не сделать, можно инфицировать малыша и спровоцировать у него развитие следующих заболеваний:
- пневмония;
- конъюнктивит;
- пиелонефрит;
- сепсис;
- менингит и другие опасные патологические состояния.
Во время внутриутробного развития уреаплазма никак не влияет на ребенка. Инфицирование происходит во время его появления на свет по родовым путям.
Уреаплазма 10 в 4 степени, нужно ли лечить
Зачастую люди задаются вопросом, если была обнаружена уреаплазма 10 в 4 степени, нужно ли ее лечить? Ведь данный показатель стоит на грани с отклонением от нормы. Как правило, в лечении в этом случае нет необходимости. Терапевтические мероприятия, если уреаплазма имеет показатели более 10 в 4 степени назначаются в следующих случаях:
- при возникновении сильного воспалительного процесса в мочеполовых путях (при условии, что в анализах не найдены другие патогенные микроорганизмы);
- при обнаружении в биологическом материале уреаплазмы у пациентов, входящих в группу людей, которым в обязательном порядке необходимо проходить диагностические мероприятия (даже без симптоматики воспалительного процесса).
Обязательному обследованию подлежит следующая группа лиц:
- женщины, у которых было невынашивание беременности в анамнезе;
- люди с подозрением на бесплодие;
- доноры спермы.
Если пациент не входит в группу этих лиц и у него не наблюдается воспалительный процесс в мочеполовых путях, то, как правило, специалист не назначает специального лечения. Могут быть только рекомендованы меры для укрепления защитных сил иммунитета. Для этого назначаются противовирусные препараты, иммуномодуляторы, комплекс витаминов и минералов. Также, надо полноценно питаться, заниматься спортом и закаляться, отказаться от пагубных пристрастий (прием наркотических веществ, употребление спиртной продукции, курение). При сильной иммунной системе ни один патогенный микроорганизм не сможет прижиться и спровоцировать развитие серьезных заболеваний.
Методы лечения
Если патогенный микроорганизм уже однажды проник в организм, то полностью от него излечиться невозможно. Терапия направлена на предотвращение размножения и распространения уреаплазмы.
Лечение может производиться антибиотиками следующих групп:
- Тетрациклин;
- Макролиды;
- Фторхинолоны;
- Аминогликозиды;
- Левомицетин.
Дополнительно назначаются иммунотропные медикаменты. Они укрепляют защитные силы организма и тем самым уменьшают риск возникновения рецидивов.
При возникновении симптоматики уреаплазмоза необходимо незамедлительно обратиться в медицинское учреждение для диагностических мероприятий. Чем раньше будет начато лечение, тем меньше риск развития осложнений.
Терапия в домашних условиях при таком патологическом состоянии может только навредить. Поэтому самолечение недопустимо. Любые методики нетрадиционной медицины должны быть только в составе с основным лечением и в обязательном порядке согласованы с лечащим специалистом.
Видео
Как берут анализ на уреаплазму у мужчин.
Исследование позволяет выявить концентрацию ДНК Ureaplasma parvum в биологическом материале. Данный вид микроорганизмов относится к группе условно-патогенных (УПМ), присутствует в микрофлоре 50-75 % взрослого населения, однако при снижении иммунитета или присоединении других инфекций активно размножается, приводя к развитию дисбиоза, а затем воспалительного процесса. Уреаплазмы обладают невысокой иммуногенностью, что затрудняет обнаружение специфических антител к ним в сыворотке крови, поэтому обнаружение генетического материала (ДНК) – наиболее чувствительный метод диагностики. Определение вида уреаплазмы имеет значение при выборе оптимальной тактики лечения.
Возбудитель уреаплазмоза, уреаплазма.
Ureaplasma parvum, DNA.
Полимеразная цепная реакция в режиме реального времени.
ГЭ/мл (геномный эквивалент на миллилитр биоматериала).
Какой биоматериал можно использовать для исследования?
Первая порция утренней мочи, соскоб из прямой кишки, соскоб урогенитальный.
Как правильно подготовиться к исследованию?
- Женщинам исследование (процедуру взятия урогенитального мазка или сбор мочи) рекомендуется производить до менструации или через 2-3 дня после её окончания.
- Мужчинам — не мочиться в течение 3 часов до взятия урогенитального мазка или сбора мочи.
Общая информация об исследовании
Ureaplasma parvum (прежде определялась как «биовар parvo») являются разновидностью уреаплазм – условно-патогенных микроорганизмов, способных паразитировать на мембране сперматозоидов и эпителия слизистой оболочки мочеполовых органов. Уреаплазмы передаются преимущественно половым путем, хотя возможен контактно-бытовой, а также вертикальный способ – от больной матери к ребенку во время беременности или родов. Источник заражения – больной уреаплазменной инфекцией или бессимптомный носитель Ureaplasma parvum (уреаплазма парвум). После инфицирования развитие инфекции происходит не во всех случаях. Ему способствуют различные иммунодефициты, нарушение факторов местной защиты, в том числе дисбиоз влагалища у женщин или хронический простатит у мужчин, сопутствующие инфекции (хламидиоз, гонорея, бактериальный вагиноз и т. д.).
Инкубационный период составляет 2-5 недель. Симптомы уреаплазменной инфекции могут быть слабо выраженными или вообще отсутствовать (характерно для женщин). У мужчин уреаплазма парвум может быть причиной воспаления уретры (негонококковый уретрит), мочевого пузыря (цистит), простаты (простатит), поражения яичек (орхит) и их придатков (эпидидимит), нарушения состава спермы (снижение подвижности и количества сперматозоидов – что грозит бесплодием), а также реактивных артритов и мочекаменной болезни. У женщин уреаплазма парвум способна вызывать воспаление влагалища (вагинит), шейки матки (цервицит), а при ослаблении иммунитета – воспаление матки (эндометрит) и ее придатков (аднексит), что может приводить к внематочной беременности или бесплодию. Кроме того, уреаплазма парвум у беременных может быть причиной выкидышей, воспаления плодных оболочек, рождения детей с низкой массой тела, а также причиной развития бронхолегочных заболеваний (воспаления легких, дисплазии), бактериемии и менингита у новорождённых.
В качестве причины воспалительных заболеваний мочеполовой системы Ureaplasma parvum рассматривают в том случае, если при лабораторном исследовании не выявляются другие патогенные микроорганизмы, способные вызвать эти заболевания. Дифференцировать Ureaplasma parvum от другого вида уреаплазм – U. urealyticum, – можно только с помощью молекулярно-генетических методов, в том числе и полимеразной цепной реакции. Определение вида уреаплазмы имеет значение при выборе оптимальной тактики лечения пациента.
Для чего используется исследование?
- Дифференцирование U. parvum от другого вида уреаплазм – U. urealyticum.
- Количественный анализ микроорганизмов данного вида.
- Чтобы установить причину хронических воспалительных заболеваний мочеполовой системы.
- Для дифференциальной диагностики заболеваний, вызванных половыми инфекциями и протекающих со сходными симптомами: хламидиоза, гонореи, микоплазменной инфекции (наряду с другими исследованиями).
- Чтобы оценить эффективность антибактериальной терапии.
- Для профилактического обследования.
Когда назначается исследование?
- При подозрении на уреаплазменную инфекцию и уреаплазмоз, в том числе после случайных половых контактов и при симптомах воспаления мочеполовой системы.
- При планировании беременности (обоим супругам).
- При бесплодии или невынашивании беременности.
- При внематочной беременности.
- При необходимости оценить эффективность антибактериальной терапии (через 1 месяц после лечения).
Что означают результаты?
Референсные значения: не более 1*10^5 ГЭ/мл.
Количество условно патогенных микроорганизмов на бланке с результатом указано в геномных эквивалентах на миллилитр биоматериала (ГЭ/мл).
Геномный эквивалент – это «объем» генетического материала, соответствующий одному геному бактерии, гриба или простейшего. Если в бактериологических исследованиях принято считать, что одной клетке возбудителя соответствует КОЕ (колониеобразующая единица), то в молекулярно-биологических исследованиях похожей единицей является ГЭ.
Выявленное методом ПЦР количество ГЭ напрямую отражает количество клеток возбудителя, в то время как КОЕ косвенно отражают количество возбудителя в образце и в значительной степени зависят от особенностей исполнения бактериологического исследования.
- Обнаружение ДНК Ureaplasma parvum в биоматериале может свидетельствовать о том, что этот микроорганизм вызвал воспалительные заболевания органов мочеполовой системы, только при наличии симптомов воспаления и при отсутствии других патогенных микроорганизмов (хламидий, микоплазм, гонококков).
- Выявление ДНК Ureaplasma parvum при отсутствии симптомов воспалительных заболеваний мочеполовой системы расценивается как носительство.
- Отсутствие ДНК Ureaplasma parvum в исследуемом биоматериале при наличии симптомов воспалительных заболеваний органов мочеполовой системы свидетельствует о том, что данный возбудитель не является причиной этих заболеваний.
Критерии постановки диагноза:
- выявление ДНК условно-патогенных микроорганизмов (УПМ) в концентрации выше 10 5 ГЭ/мл (порог клинической значимости, что соответствует 10 4 КОЕ/мл);
- клинические и лабораторные признаки воспалительного процесса;
- отягощенный анамнез (невынашивание, преждевременные роды и т.д.).
При наличии специфических клинических проявлений анализ можно дополнить исследованиями на микоплазмы (Флороценоз), сифилис, вирусы герпеса, ВПЧ.
Кто назначает исследование?
Акушер-гинеколог, уролог, венеролог, педиатр-неонатолог, инфекционист.